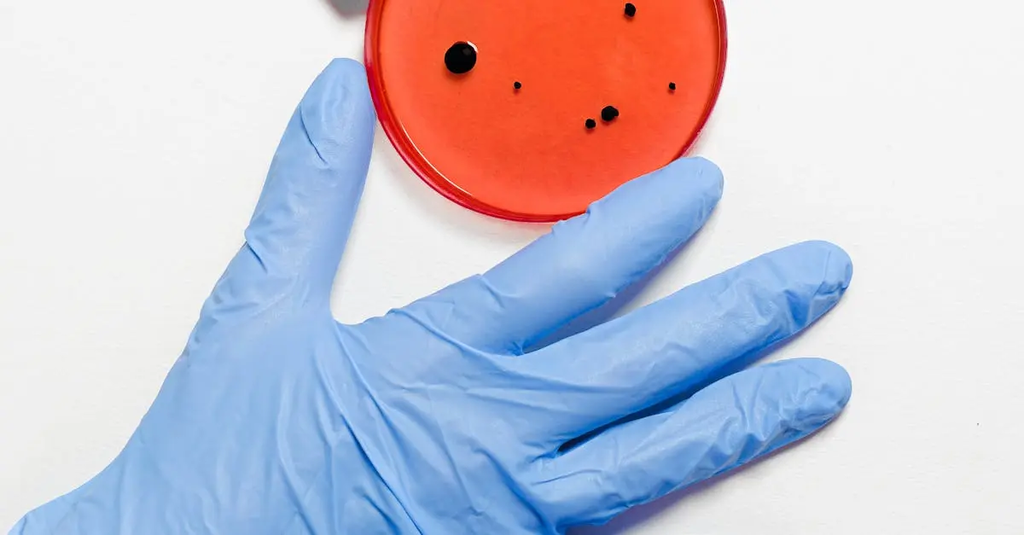

Antimicrobial Stewardship
Antimicrobial stewardship refers to coordinated strategies and interventions designed to optimize the use of antimicrobial medications, such as antibiotics, to treat infections. Its primary goals are to improve patient outcomes, reduce microbial resistance, and decrease the spread of infections caused by multidrug-resistant organisms. By ensuring the appropriate selection, dosage, and duration of antimicrobial treatments, stewardship programs help preserve the effectiveness of existing drugs and promote responsible healthcare practices.
Antimicrobial Stewardship
Antimicrobial stewardship refers to coordinated strategies and interventions designed to optimize the use of antimicrobial medications, such as antibiotics, to treat infections. Its primary goals are to improve patient outcomes, reduce microbial resistance, and decrease the spread of infections caused by multidrug-resistant organisms. By ensuring the appropriate selection, dosage, and duration of antimicrobial treatments, stewardship programs help preserve the effectiveness of existing drugs and promote responsible healthcare practices.
💡 Key Takeaways
- Define antimicrobial stewardship and its main goals: better patient outcomes, reduced resistance, and less spread of infections.
- Identify core strategies: appropriate agent choice, dosing, de-escalation, IV-to-PO switch, and optimized duration.
- Understand the roles of a multidisciplinary stewardship team (physicians, pharmacists, microbiologists, infection prevention) in implementation.
- Explain how stewardship improves patient safety and public health through surveillance, rapid diagnostics, and education.
❓ Frequently Asked Questions
What is antimicrobial stewardship?
A coordinated set of practices designed to optimize antimicrobial use to improve patient outcomes, reduce resistance, and prevent the spread of infections.
What are the goals of antimicrobial stewardship?
To improve patient outcomes, reduce antimicrobial resistance, and decrease transmission of infections, while ensuring safe, effective, and economical use of antibiotics.
What strategies are commonly used in antimicrobial stewardship?
Guidelines and protocols, audits with feedback, dose and duration optimization, de-escalation to narrower agents, rapid diagnostics, and education for clinicians and staff.
What is de-escalation and why is it important?
De-escalation means narrowing therapy based on culture results or clinical response, reducing broad-spectrum exposure and resistance risk while minimizing side effects.
Who is involved in antimicrobial stewardship and where is it applied?
A multidisciplinary team (physicians, pharmacists, microbiologists, infection preventionists) working in hospitals, clinics, long-term care, and community settings.
